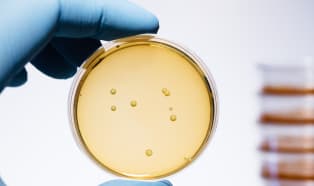

Innowacyjne rozwiązania wspomagające recykling stosowane w branży etykiet
Codziennie na całym świecie zużywa się ogromne ilości butelek PET. Według dostępnych źródeł, co sekundę zostaje wyprodukowane 16 tysięcy pojemników.

Codziennie na całym świecie zużywa się ogromne ilości butelek PET. Według dostępnych źródeł, co sekundę zostaje wyprodukowane 16 tysięcy pojemników.

Model ten umożliwia sprzedawcom utrzymanie klientów w ramach bezpiecznej pracy zdalnej

Od 6 czerwca targi w Polsce nareszcie mogą powrócić do naszych biznesowych kalendarzy! Małymi krokami gospodarka stara się odzyskać stan sprzed pandemii. Firmy aktywnie poszukują kontaktu z nowymi klientami i kierują swoją uwagę w stronę wydarzeń B2B.

Codziennością stają się pojemniki na żywność wyprodukowane z trzciny cukrowej, czy sześciopak piwa zapakowany w jadalną siatkę.

NiceLabel, producent oprogramowania do projektowania etykiet i systemów do zarządzania etykietami, oferuje bezpłatne subskrypcje swojego rozwiązania do etykietowania i usługi doradztwa technicznego organizacjom, które dołączyły do walki z COVID-19.

Würth IT wybrał firmę NiceLabel, czołowego globalnego producenta oprogramowania do projektowania etykiet i systemów do zarządzania etykietami, aby pomogła mu w tworzeniu nowego, opartego na Internecie, ustandaryzowanego procesu etykietowania dla dostawców.
![Packaging [R]evolution - o innowacjach i trendach w branży opakowań](https://res.cloudinary.com/plast/image/upload/c_fill,d_default.png,dpr_auto,f_auto,g_auto:classic,h_186,q_auto,w_314/v1/plastech/images/news/14758/revolution.jpg)
To już kolejna edycja Packaging [R]evolution, konferencji poświęconej tematyce związanej z drukiem etykiet oraz opakowań, uszlachetnieniem i zdobieniem oraz szeroko rozumianym designem.

Firma farmaceutyczna, Boehringer Ingelheim, wybrała NiceLabel, wiodącego światowego producenta oprogramowania do projektowania etykiet i systemów zarządzania etykietami, do pomocy w stworzeniu globalnego znormalizowanego procesu etykietowania.

Firma NiceLabel, producent oprogramowania do projektowania etykiet i systemów zarządzania etykietami, zapowiedziała wprowadzenie na rynek pakietu ABAP w wersji 2. Nowa wersja obsługuje zarówno rozwiązania SAP ECC, jak i SAP S/4HANA.

Tegoroczna, 32 edycja Międzynarodowych Targów Pakowania i Etykietowania Taropak) odbyła się w bloku Targów wraz z Targami Polagra - Tech, Polagra - Food, Polagra Gastro i Invest Hotel, w dniach 30 września - 3 października 2019 w Poznaniu.

Jak podają organizatorzy, około 44 000 odwiedzających skorzystało z okazji, aby poznać innowacje i trendy w branży opakowań na targach FachPack, które odbyły się w Norymberdze w dniach 24-26 września 2019 roku.
Globalna firma biotechnologiczna, Chr. Hansen, wybrała NiceLabel, wiodącego światowego producenta oprogramowania do projektowania etykiet i systemów zarządzania etykietami, na dostawcę rozwiązania do zarządzania etykietami w sieci.